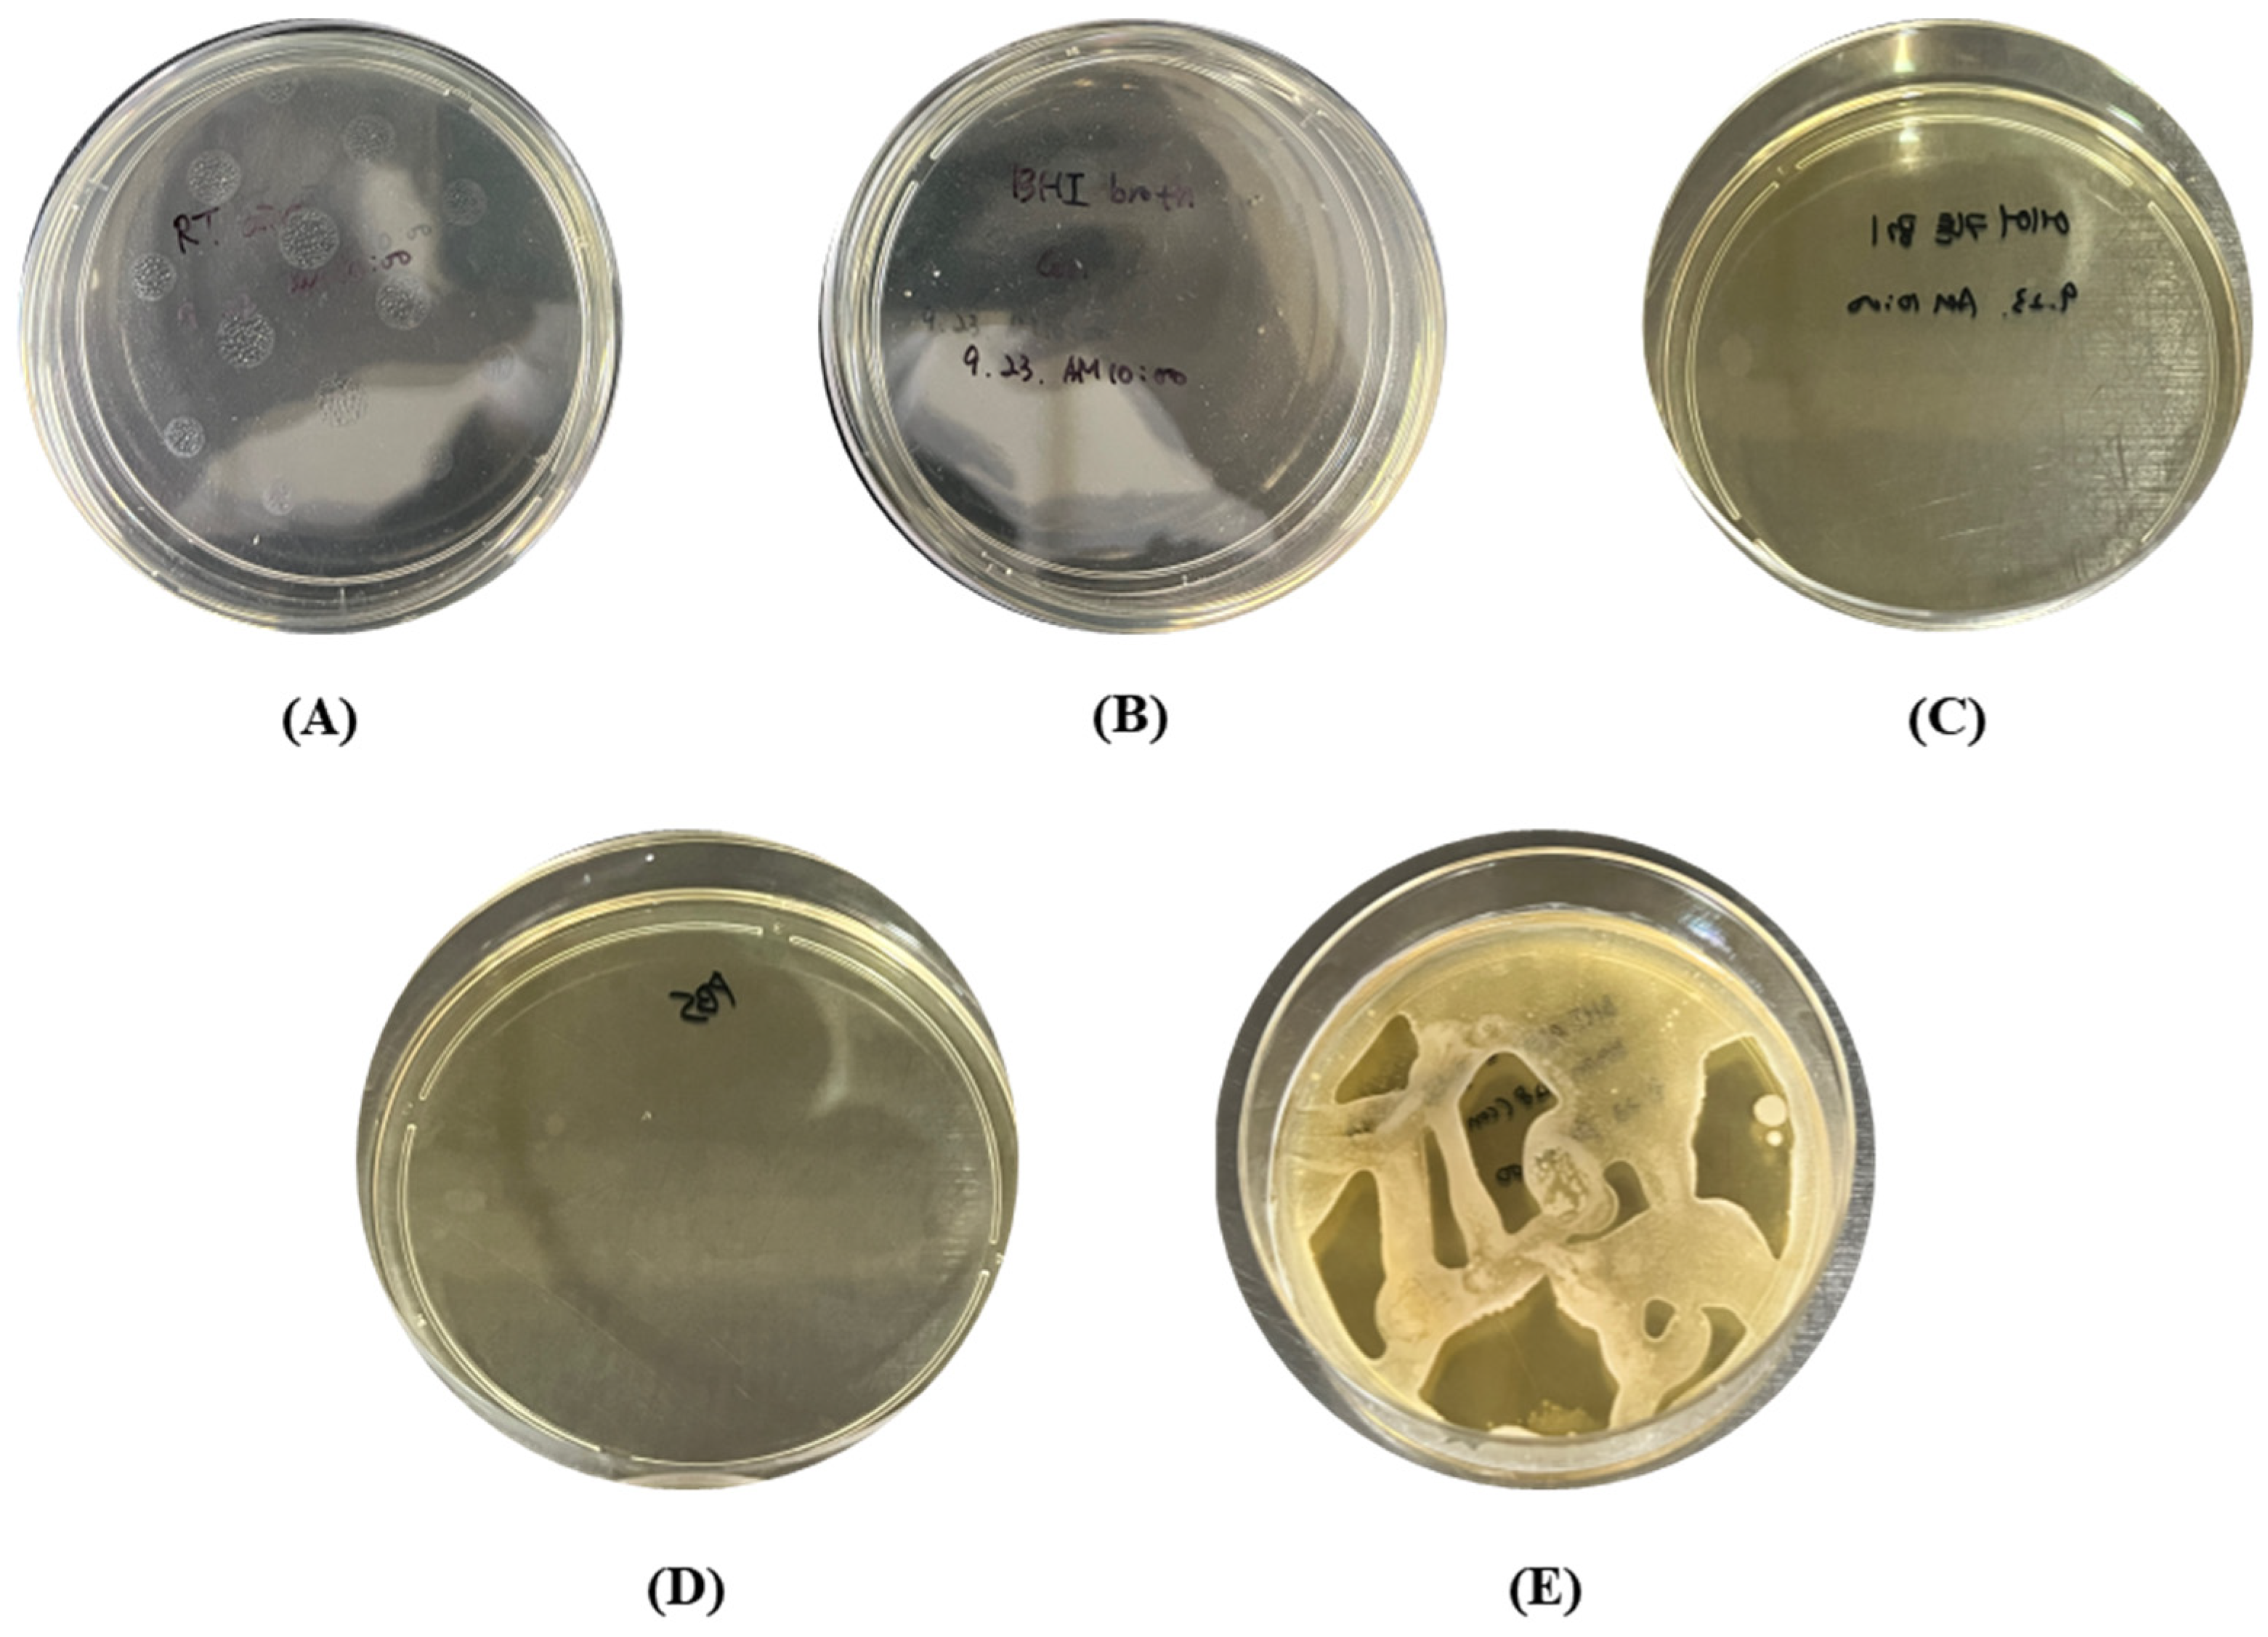
Bioengineering 10 00947 g008

The Effectiveness of a Novel Air-Barrier Device for Aerosol Reduction in a Dental Environment: Computational Fluid Dynamics Simulation
Abstract
1. Introduction
2. Materials and Methods
2.1. The CFD Simulation for the Better Design of Air-Barrier Devices
2.2. Experiment Set-Up of Droplet Blocking Effect for Evaluation of Air-Barrier Device
2.3. Experiment Set-Up to Evaluate Bacterial Barrier Effectiveness of Air-Barrier Device
2.4. Statistical Analysis
3. Results and Discussion
3.1. The Results of CFD Simulation of Air-Barrier Devices
3.2. The Results for the Droplet Blocking Effect of the Air-Barrier Device
3.3. The Results for Bacterial Barrier Effectiveness of the Air-Barrier Device
4. Conclusions
5. Patents
Supplementary Materials
Author Contributions
Funding
Institutional Review Board Statement
Informed Consent Statement
Data Availability Statement
Conflicts of Interest
References
- Harrel, S.K.; Molinari, J. Aerosols and Splatter in Dentistry. J. Am. Dent. Assoc. 2004, 135, 429–437. [Google Scholar] [CrossRef] [PubMed]
- Narayana, T.; Mohanty, L.; Sreenath, G.; Vidhyadhari, P. Role of Preprocedural Rinse and High Volume Evacuator in Reducing Bacterial Contamination in Bioaerosols. J. Oral Maxillofac. Pathol. 2016, 20, 59–65. [Google Scholar] [CrossRef] [PubMed]
- Hallier, C.; Williams, D.W.; Potts, A.J.C.; Lewis, M.A.O. A Pilot Study of Bioaerosol Reduction Using an Air Cleaning System during Dental Procedures. Br. Dent. J. 2010, 209, E14. [Google Scholar] [CrossRef] [PubMed]
- Zemouri, C.; Volgenant, C.M.C.; Buijs, M.J.; Crielaard, W.; Rosema, N.A.M.; Brandt, B.W.; Laheij, A.M.G.A.; De Soet, J.J. Dental Aerosols: Microbial Composition and Spatial Distribution. J. Oral Microbiol. 2020, 12, 1762040. [Google Scholar] [CrossRef] [PubMed]
- Zemouri, C.; de Soet, H.; Crielaard, W.; Laheij, A. A Scoping Review on Bio-Aerosols in Healthcare and the Dental Environment. PLoS ONE 2017, 12, e0178007. [Google Scholar] [CrossRef]
- Desarda, H.; Gurav, A.; Dharmadhikari, C.; Shete, A.; Gaikwad, S. Efficacy of High-Volume Evacuator in Aerosol Reduction: Truth or Myth? A Clinical and Microbiological Study. J. Dent. Res. Dent. Clin. Dent. Prospect. 2014, 8, 176–179. [Google Scholar] [CrossRef]
- Yue, L. Ventilation in the Dental Clinic: An Effective Measure to Control Droplets and Aerosols during the Coronavirus Pandemic and Beyond. Chin. J. Dent. Res. 2020, 23, 105–107. [Google Scholar] [CrossRef]
- Avasthi, A. High Volume Evacuator (HVE) in Reducing Aerosol- an Exploration Worth by Clinicians. J. Dent. Health Oral Disord. Ther. 2018, 9, 165–166. [Google Scholar] [CrossRef]
- Balanta-Melo, J.; Gutiérrez, A.; Sinisterra, G.; Díaz-Posso, M.d.M.; Gallego, D.; Villavicencio, J.; Contreras, A. Rubber Dam Isolation and High-Volume Suction Reduce Ultrafine Dental Aerosol Particles: An Experiment in a Simulated Patient. Appl. Sci. 2020, 10, 6345. [Google Scholar] [CrossRef]
- Wang, Y.; Li, C.; Yuan, H.; Wong, M.C.; Zou, J.; Shi, Z.; Zhou, X. Rubber Dam Isolation for Restorative Treatment in Dental Patients. Cochrane Database Syst. Rev. 2016, 9, CD009858. [Google Scholar] [CrossRef]
- Ge, Z.; Yang, L.; Xia, J.; Fu, X.; Zhang, Y. Possible Aerosol Transmission of COVID-19 and Special Precautions in Dentistry. J. Zhejiang Univ. Sci. B 2020, 21, 361–368. [Google Scholar] [CrossRef]
- Liu, M.-H.; Chen, C.-T.; Chuang, L.-C.; Lin, W.-M.; Wan, G.-H. Removal Efficiency of Central Vacuum System and Protective Masks to Suspended Particles from Dental Treatment. PLoS ONE 2019, 14, e0225644. [Google Scholar] [CrossRef]
- Tartaglia, G.M.; Tadakamadla, S.K.; Connelly, S.T.; Sforza, C.; Martín, C. Adverse Events Associated with Home Use of Mouthrinses: A Systematic Review. Ther. Adv. Drug Saf. 2019, 10, 204209861985488. [Google Scholar] [CrossRef]
- Rupf, S.; Berger, H.; Buchter, A.; Harth, V.; Ong, M.F.; Hannig, M. Exposure of Patient and Dental Staff to Fine and Ultrafine Particles from Scanning Spray. Clin. Oral Investig. 2015, 19, 823–830. [Google Scholar] [CrossRef]
- Polednik, B. Exposure of Staff to Aerosols and Bioaerosols in a Dental Office. Build. Environ. 2021, 187, 107388. [Google Scholar] [CrossRef]
- Krajewski, G.; Węgrzyński, W. Air Curtain as a Barrier for Smoke in Case of Fire: Numerical Modelling. Bull. Pol. Acad. Sci. Tech. Sci. 2015, 63, 145–153. [Google Scholar] [CrossRef]
- Wang, L.; Zhong, Z. An Approach to Determine Infiltration Characteristics of Building Entrance Equipped with Air Curtains. Energy Build. 2014, 75, 312–320. [Google Scholar] [CrossRef]
- Hayes, F.C. Heat Transfer Characteristics of the Air Curtain: A Plane Jet Subjected to Transverse Pressure and Temperature Gradients. Ph.D. Thesis, University of Illinois, Urbana, IL, USA, 1968. [Google Scholar]
- Krajewski, G. Air Barriers Used for Separating Smoke Free Zones in Case of Fire in Tunnel. In Proceedings of the Tunnel Safety and Ventilation, Graz, Austria, 12 May 2014; Technische Universität Graz: Graz, Austria, 2014; pp. 110–117. [Google Scholar]
- Krajewski, G.; Sztarbala, G. Air Curtains Used for Separating Smoke Free Zones in Case of Fire. In Proceedings of the Building Simulation 2011, Sydney, Australia, 14 November 2011; International Building Performance Simulation Association: Sydney, Australia, 2011; pp. 2773–2777. [Google Scholar]
- Feng, G.; Liao, Q.; Hu, S. Numerical Simulation of Particulate Matter 2.5 Distribution in a Roadway. Sci. Rep. 2018, 8, 13220. [Google Scholar] [CrossRef]
- Huang, Y.; Ng, E.C.Y.; Surawski, N.C.; Yam, Y.-S.; Mok, W.-C.; Liu, C.-H.; Zhou, J.L.; Organ, B.; Chan, E.F.C. Large Eddy Simulation of Vehicle Emissions Dispersion: Implications for on-Road Remote Sensing Measurements. Environ. Pollut. 2020, 259, 113974. [Google Scholar] [CrossRef]
- COMSOL CFD Module User’s Guide, Version: COMSOL 5.3. Available online: https://doc.comsol.com/5.3/doc/com.comsol.help.cfd/CFDModuleUsersGuide.pdf (accessed on 9 October 2020).
- Richardson, J.F.; Harker, J.H.; Backhurst, J.R.; Coulson, J.M. Coulson & Richardson’s Chemical Engineering, Vol 2: Particle Technology & Separation Processes, 5th ed.; Butterworth-Heinemann: Oxford, UK, 2002. [Google Scholar]
- Bahl, P.; Bhattacharjee, S.; de Silva, C.; Chughtai, A.A.; Doolan, C.; MacIntyre, C.R. Face Coverings and Mask to Minimise Droplet Dispersion and Aerosolisation: A Video Case Study. Thorax 2020, 75, 1024–1025. [Google Scholar] [CrossRef]
- Park, S.-N.; Lee, D.; Lim, Y.-K.; Kim, H.-S.; Cho, E.; Jin, D.; Kim, S.-G.; Kook, J.-K. Antimicrobial Effect of Carvacrol against Cariogenic and Periodontopathic Bacteria. Korean J. Microbiol. 2012, 48, 52–56. [Google Scholar] [CrossRef]
- Park, T.-Y.; Lim, Y.K.; Kook, J.-K. Antimicrobial Effect of Polyphenon 60 against Streptococcus Mutans and Streptococcus Sobrinus. Int. J. Oral Biol. 2018, 43, 123–127. [Google Scholar] [CrossRef]
- Ionescu, A.C.; Cagetti, M.G.; Ferracane, J.L.; Garcia-Godoy, F.; Brambilla, E. Topographic Aspects of Airborne Contamination Caused by the Use of Dental Handpieces in the Operative Environment. J. Am. Dent. Assoc. 2020, 151, 660–667. [Google Scholar] [CrossRef] [PubMed]
- Abramovich, G.N. The Theory of Turbulent Jets; M.I.T. Press: Cambridge, MA, USA, 1963. [Google Scholar]
- Rajaratnam, N. Turbulent Jets; Elsevier Science: Amsterdam, The Netherlands, 1976; ISBN 9780080869964. [Google Scholar]
- Schlichting, H. Boundary-Layer Theory, 6th ed.; McGraw-Hill Series in Mechanical Engineering; Vesper, K.H., Ed.; McGraw-Hill: New York, NY, USA, 1968. [Google Scholar]
- Helmis, C.G.; Tzoutzas, J.; Flocas, H.A.; Halios, C.H.; Stathopoulou, O.I.; Assimakopoulos, V.D.; Panis, V.; Apostolatou, M.; Sgouros, G.; Adam, E. Indoor Air Quality in a Dentistry Clinic. Sci. Total Environ. 2007, 377, 349–365. [Google Scholar] [CrossRef]
- Lang, A.; Ovsenik, M.; Verdenik, I.; Remškar, M.; Oblak, Č. Nanoparticle Concentrations and Composition in a Dental Office and Dental Laboratory: A Pilot Study on the Influence of Working Procedures. J. Occup. Environ. Hyg. 2018, 15, 441–447. [Google Scholar] [CrossRef]
- Sotiriou, M.; Ferguson, S.F.; Davey, M.; Wolfson, J.M.; Demokritou, P.; Lawrence, J.; Sax, S.N.; Koutrakis, P. Measurement of Particle Concentrations in a Dental Office. Environ. Monit. Assess. 2008, 137, 351–361. [Google Scholar] [CrossRef]
- Riley, W.J.; McKone, T.E.; Lai, A.C.K.; Nazaroff, W.W. Indoor Particulate Matter of Outdoor Origin: Importance of Size-Dependent Removal Mechanisms. Environ. Sci. Technol. 2002, 36, 200–207. [Google Scholar] [CrossRef]
- Chen, S.; Butterworth, A.; Jiang, L. Air Quality Indices and Cleanroom Ventilation Equations, and Their Application in a Cleanroom HVAC System, Part One: Theoretical Considerations. Clean Air Contain. Rev. 2019, 37, 3–10. [Google Scholar]
- Yaglou, C.P.; Witheridge, W.N. Ventilation Requirements (Part 2); AIVC: Ghent, Belgium, 1937; Volume 42, pp. 423–436. [Google Scholar]
- Montalli, V.A.M.; Garcez, A.S.; de Oliveira, L.V.C.; Sperandio, M.; Napimoga, M.H.; Motta, R.H.L. A Novel Dental Biosafety Device to Control the Spread of Potentially Contaminated Dispersion Particles from Dental Ultrasonic Tips. PLoS ONE 2021, 16, e0247029. [Google Scholar] [CrossRef]
- Din, A.R.; Hindocha, A.; Patel, T.; Sudarshan, S.; Cagney, N.; Koched, A.; Mueller, J.-D.; Seoudi, N.; Morgan, C.; Shahdad, S.; et al. Quantitative Analysis of Particulate Matter Release during Orthodontic Procedures: A Pilot Study. Br. Dent. J. 2020. [Google Scholar] [CrossRef]
- Crawford, C.; Vanoli, E.; Decorde, B.; Lancelot, M.; Duprat, C.; Josserand, C.; Jilesen, J.; Bouadma, L.; Timsit, J.-F. Modeling of Aerosol Transmission of Airborne Pathogens in ICU Rooms of COVID-19 Patients with Acute Respiratory Failure. Sci. Rep. 2021, 11, 11778. [Google Scholar] [CrossRef] [PubMed]
- Seo, J.H.; Jeon, H.W.; Choi, J.S.; Sohn, J.-R. Prediction Model for Airborne Microorganisms Using Particle Number Concentration as Surrogate Markers in Hospital Environment. Int. J. Environ. Res. Public Health 2020, 17, 7237. [Google Scholar] [CrossRef] [PubMed]
- Wikuats, C.F.H.; Duarte, E.H.; Prates, K.V.M.C.; Janiaski, L.L.L.; de Oliveira Gabriel, B.; da Cunha Molina, A.; Martins, L.D. Assessment of Airborne Particles and Bioaerosols Concentrations in a Waste Recycling Environment in Brazil. Sci. Rep. 2020, 10, 14812. [Google Scholar] [CrossRef] [PubMed]
- Tang, J.W.; Liebner, T.J.; Craven, B.A.; Settles, G.S. A Schlieren Optical Study of the Human Cough with and without Wearing Masks for Aerosol Infection Control. J. R. Soc. Interface 2009, 6, S727–S736. [Google Scholar] [CrossRef] [PubMed]
- Baik, S.Y.; Park, Y.; Choi, S.H.; Kim, H.J.; Kim, S.T. Effect of Quaternary Ammonium Compounds on Microbial Contamination Levels in Dental Clinics. J. Dent. Rehabil. Appl. Sci. 2020, 36, 55–60. [Google Scholar] [CrossRef]
- Kellett, M.; Holbrook, W.P. Bacterial Contamination of Dental Handpieces. J. Dent. 1980, 8, 249–253. [Google Scholar] [CrossRef]
- Larato, D.C.; Ruskin, P.F.; Martin, A. Effect of an Ultrasonic Scaler on Bacterial Counts in Air. J. Periodontol. 1967, 38, 550–554. [Google Scholar] [CrossRef]
- Leggat, P.A.; Kedjarune, U. Bacterial Aerosols in the Dental Clinic: A Review. Int. Dent. J. 2001, 51, 39–44. [Google Scholar] [CrossRef]

| Group | Repetition | Side | Number of Particles |
|---|---|---|---|
| Before air-barrier | 1 | Front | 305 |
| Left | 12 | ||
| Right | 6 | ||
| Back | 0 | ||
| 2 | Front | 1394 | |
| Left | 15 | ||
| Right | 4 | ||
| Back | 0 | ||
| 3 | Front | 2575 | |
| Left | 0 | ||
| Right | 0 | ||
| Back | 0 | ||
| After air-barrier | 1 | Front | 3 |
| Left | 0 | ||
| Right | 0 | ||
| Back | 0 | ||
| 2 | Front | 0 | |
| Left | 1 | ||
| Right | 2 | ||
| Back | 0 | ||
| 3 | Front | 0 | |
| Left | 0 | ||
| Right | 0 | ||
| Back | 0 |
| Group | N | 25% | 75% | Mean (Median) |
|---|---|---|---|---|
| Before air-barrier | 12 | 0.00 | 232.50 | 359.25 (5.00) |
| After air-barrier | 12 | 0.00 | 0.75 | 0.50 (0.00) |
| p-value between two groups | 0.028 * | |||
| Measurement Sites | Before Air-Barrier Device (CFU/cm2) | After Air-Barrier Device (CFU/cm2) | |
|---|---|---|---|
| Front | #1-Left | 364 | 1 |
| #2-Right | 585 | 1 | |
| Left | #3-Left | 14 | 1 |
| #4-Right | 32 | 0 | |
| Right | #5-Left | 15 | 1 |
| #6-Right | 8 | 0 | |
| Back | #7-Left | 7 | 0 |
| #8-Right | 1 | 0 | |
Disclaimer/Publisher’s Note: The statements, opinions and data contained in all publications are solely those of the individual author(s) and contributor(s) and not of MDPI and/or the editor(s). MDPI and/or the editor(s) disclaim responsibility for any injury to people or property resulting from any ideas, methods, instructions or products referred to in the content. |
© 2023 by the authors. Licensee MDPI, Basel, Switzerland. This article is an open access article distributed under the terms and conditions of the Creative Commons Attribution (CC BY) license (https://creativecommons.org/licenses/by/4.0/).
Share and Cite
Ma, X.; Kim, W.-H.; Lee, J.-H.; Han, D.-W.; Lee, S.-H.; Kim, J.; Lee, D.; Kim, B.; Shin, D.-M. The Effectiveness of a Novel Air-Barrier Device for Aerosol Reduction in a Dental Environment: Computational Fluid Dynamics Simulation. Bioengineering 2023, 10, 947. https://doi.org/10.3390/bioengineering10080947
Ma X, Kim W-H, Lee J-H, Han D-W, Lee S-H, Kim J, Lee D, Kim B, Shin D-M. The Effectiveness of a Novel Air-Barrier Device for Aerosol Reduction in a Dental Environment: Computational Fluid Dynamics Simulation. Bioengineering. 2023; 10(8):947. https://doi.org/10.3390/bioengineering10080947
Chicago/Turabian StyleMa, Xiaoting, Won-Hyeon Kim, Jong-Ho Lee, Dong-Wook Han, Sung-Ho Lee, Jisung Kim, Dajung Lee, Bongju Kim, and Dong-Myeong Shin. 2023. "The Effectiveness of a Novel Air-Barrier Device for Aerosol Reduction in a Dental Environment: Computational Fluid Dynamics Simulation" Bioengineering 10, no. 8: 947. https://doi.org/10.3390/bioengineering10080947
APA StyleMa, X., Kim, W.-H., Lee, J.-H., Han, D.-W., Lee, S.-H., Kim, J., Lee, D., Kim, B., & Shin, D.-M. (2023). The Effectiveness of a Novel Air-Barrier Device for Aerosol Reduction in a Dental Environment: Computational Fluid Dynamics Simulation. Bioengineering, 10(8), 947. https://doi.org/10.3390/bioengineering10080947

